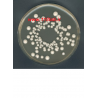
وای جی سی اگار YGC agar Yeast extract glucose chloramphenicol agar 116000 Merck

تریبتون واتر Tryptone water MERCK 110859
0 ریال
(بدون مالیات)

سترماید اگار Cetrimide agar MERCK 105284
0 ریال
(بدون مالیات)

ای ام بی اگار EMB Eosin Methylene blue agar...
0 ریال
(بدون مالیات)